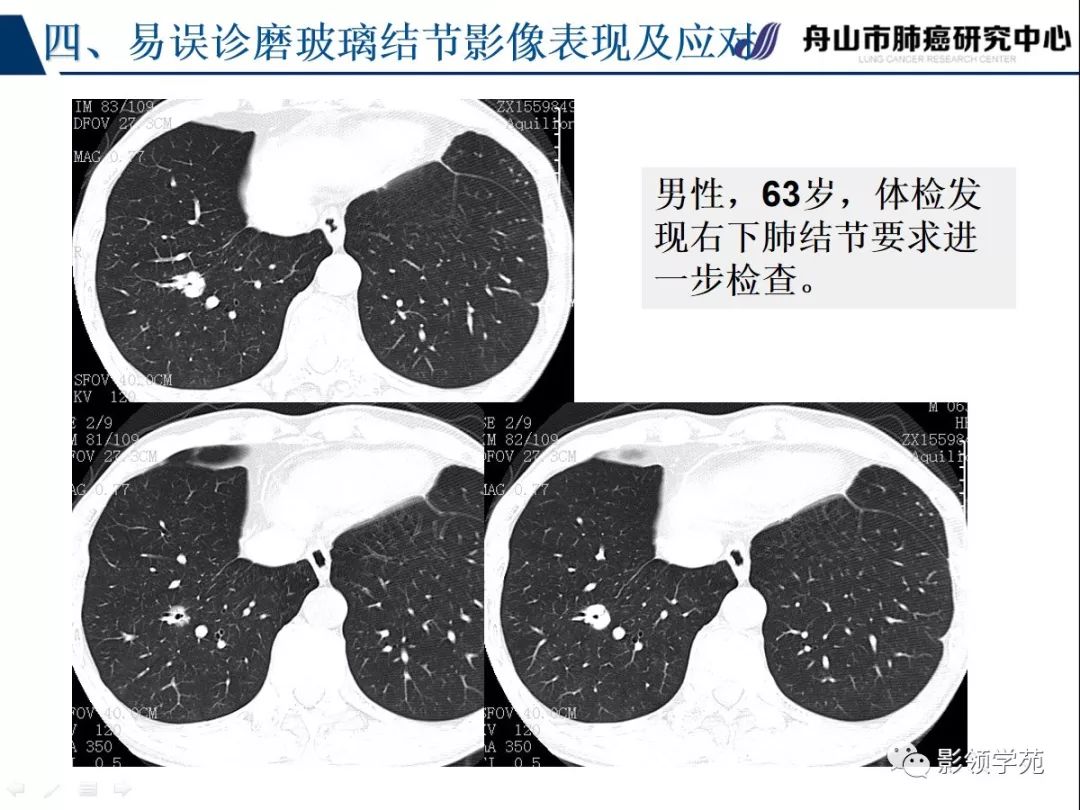
肺良恶性结节ct征象及鉴别诊断

良性结节CT图

一照ct肺有小结节我会是肺癌吗
图片尺寸1840x3264肺结节到底是良性,还是恶性,如何辨别?这些特征需警惕
图片尺寸640x687
ct扫描发现右上肺小结节.
图片尺寸1544x2054
ct:右下肺实性结节11mm.
图片尺寸1080x918
0304.对应的ct影像-2 典型的实性结节和磨玻璃影的c - 抖音
图片尺寸1310x1122
【讨论】ct体检发现肺部结节
图片尺寸512x512
2021年胸部ct2022年复查胸部ct术中冰冻证实良性结节本文是郑弘洋版权
图片尺寸1200x1600
肺磨玻璃结节的ct诊断
图片尺寸960x720
【读片】腹部平扫 增强ct,发现多发结节及肿块,已补充胸部ct,大家来
图片尺寸2058x3086刘懿博士说肺癌一三亖一肺结节ct报告是良性我力主手
图片尺寸1735x1169
【影像读片】分享一例典型结节病的ct和气管镜表现
图片尺寸2500x2560
青年男性胸部结节ct检查
图片尺寸529x413
少见良性肺结节ct表现影像天地
图片尺寸960x720
肺良恶性结节ct征象及鉴别诊断
图片尺寸1080x810
肺良恶性结节ct征象及鉴别诊断
图片尺寸1016x762
12.18 ct发现大小近1cm的结节
图片尺寸512x512
肺良性磨玻璃ct表现——容易误诊为肺癌的磨玻璃结节
图片尺寸602x580
ct扫描发现右上肺小结节.
图片尺寸2100x1657
这种肺部结节危险吗上次胸疼去ct看的
图片尺寸1728x2304
如果随访,有肺癌转移风险;如果直接手术,又有很多炎症性良性结节,被
图片尺寸1080x1510
猜你喜欢:良性实性肺结节图片恶性肺结节图片肺结节图片和正常图片肺部小结节恶性良性肺结节图片肺结节真实图片良性肺结节ct图片肺结节ct怎么看图解肺结节长什么样子图片良性肺结节图片良性结节CT图肺结节ct图片肺结节ct片图片图解肺部结节ct图片图解乳腺结节良性的图片肺结节良性与恶性鉴别肺结节ct图片肺部肺结节ct肺结节ct图片螺旋肺结节图片高清图片肺部结节ct图片怎么看肺结节ct报告单图片肺结节手术图片怎样看懂肺结节ct图片肺结节图片肺部恶性肿瘤ct图片肺结核的ct图片磨玻璃结节恶性乳腺结节取出图片乳腺增生结节真人图乔欣深v员工墙图片餐厅门牌图片电焊焊管子的焊法图解釜山艺术高中的爱豆led电源接法图100英镑快手编辑个人资料大全吸入式喷砂枪原理江诗丹顿纵横四海49150硕士服穿法元歌海报壁纸